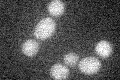
YGR006W
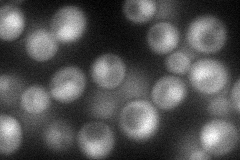
YGR006W
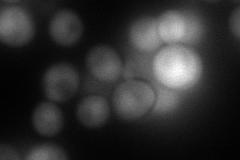
YGR006W
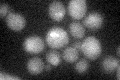
YGR006W

View description
Splicing factor involved in the positioning of the 3' splice site during the second catalytic step of splicing, part of snRNP U5, interacts with Slu7p
Localization:
Intensity:
Fold change:
Significance:
-
C’ GFP library in SD
below threshold17.18 -
N' NOP1pr-GFP in SD
cytosol,nucleus52.6924 -
N' TEF2pr-mCherry in SD
nucleus81.0267 -
N' NATIVEpr-GFP in SD

nucleus24.8045 -
N' TEF2pr-VC and Cyto-VN in SD

nucleus42.7817 -
C’ GFP library in SD+DTT
cytosol16.840.97No -
C’ GFP library in SD+H2O2

cytosolN/AN/ANo -
C’ GFP library in Starvation Media

cytosol15.560.9No -
C’ GFP library on the background of Pup2-DaMP

below threshold -
C’ GFP library on the background of CCT mutant

below threshold18.72911.08954No
